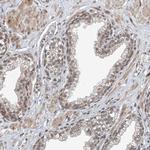
TAF8 Antibody in Immunohistochemistry (Paraffin) (IHC (P))

Search
Invitrogen
TAF8 Polyclonal Antibody
{{$productOrderCtrl.translations['antibody.pdp.commerceCard.promotion.promotions']}}
{{$productOrderCtrl.translations['antibody.pdp.commerceCard.promotion.viewpromo']}}
{{$productOrderCtrl.translations['antibody.pdp.commerceCard.promotion.promocode']}}: {{promo.promoCode}} {{promo.promoTitle}} {{promo.promoDescription}}. {{$productOrderCtrl.translations['antibody.pdp.commerceCard.promotion.learnmore']}}
产品信息
PA5-56837
种属反应
宿主/亚型
分类
类型
抗原
偶联物
形式
浓度
规格
纯化类型
保存液
内含物
保存条件
运输条件
RRID
产品详细信息
Immunogen sequence: PHTYIKTPTY REPVSDYQVL REKAASQRRD VERALTRFMA KTGETQSLFK DDVSTFPLIA ARPFTIPYL
Highest antigen sequence identity to the following orthologs: Mouse - 99%, Rat - 100%.
靶标信息
Transcription factor TFIID is one of the general factors required for accurate and regulated initiation by RNA polymerase II. Mediates both basal and activator-dependent transcription. Plays a role in the differentiation of preadipocyte fibroblasts to adipocytes, however, does not seem to play a role in differentiation of myoblasts. Required for the integration of TAF10 in the TAF complex. May be important for survival of cells of the inner cell mass which constitute the pluripotent cell population of the early embryo.
仅用于科研。不用于诊断过程。未经明确授权不得转售。
篇参考文献 (0)
生物信息学
蛋白别名: hTAFII43; Protein taube nuss; TAF8 RNA polymerase II, TATA box binding protein (TBP)-associated factor, 43kDa; TAFII-43; TATA box binding protein (TBP)-associated factor, RNA polymerase II, A, 45/50kDa; taube nuss homolog; TBP-associated factor 43 kDa; TBP-associated factor 8; TBP-associated factor TAFII43; TBP-associated factor, RNA polymerase II, 43 kD; Transcription initiation factor TFIID 43 kDa subunit; Transcription initiation factor TFIID subunit 8; unnamed protein product
基因别名: II; NEDMLHB; TAF; TAF(II)43; TAF8; TAFII-43; TAFII43; TBN
UniProt ID: (Human) Q7Z7C8
Entrez Gene ID: (Human) 129685